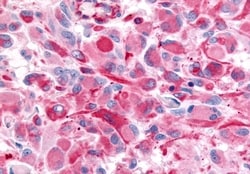
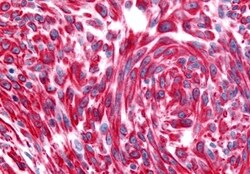

Promotional price valid on web orders only. Your contract pricing may differ. Interested in signing up for a dedicated account number?
Learn More
Learn More
Invitrogen™ CHRM2 Polyclonal Antibody


Rabbit Polyclonal Antibody
Supplier: Invitrogen™ PA533428
Description
CHRM2 Polyclonal Antibody for IHC (P)
Muscarinic cholinergic receptor 2 (CHRM2) is an Acetylcholine Receptor has been suggested to function as a presynaptic autoreceptor that inhibits acetylcholine release. The M2 receptor has also been suggested to mediate smooth muscle contractility. Alzheimer's disease (AD) involves selective loss of M2 subtype receptors in cortical and hippocampal regions of the human brain. Increase in M2 receptor heterozygosity has been associated with depression in women. The M2 receptor has been reported to be expressed in various regions of the brain including the cerebellum, cerebral cortex, hippocampus, medulla, striatum, and thalamus, and in lung and prostate.
Specifications
| CHRM2 | |
| Polyclonal | |
| Unconjugated | |
| CHRM2 | |
| 7TM receptor; acetylcholine receptor; acetylcholine receptor, muscarinic 2; AChR M2; AChR-M2; Acm2; cardiac muscarinic acetylcholine receptor; cholinergic receptor; cholinergic receptor muscarinic 2; cholinergic receptor, muscarinic 2; cholinergic receptor, muscarinic 2, cardiac; cholinergic receptor, muscarinic 2, isoform a; Chrm2; Chrm-2; FLJ43243; HM2; M2; M2 muscarinic acetylcholine receptor; m2AChR; M2-mAChR; MGC120006; MGC120007; muscarinic acetylcholine receptor 2; muscarinic acetylcholine receptor m2; muscarinic M2 receptor; muscarinic receptor m2; unnamed protein product | |
| Rabbit | |
| Antigen Affinity Chromatography | |
| RUO | |
| 100342878, 100715343, 100770997, 101102897, 1129, 243764, 397498, 403858, 522170, 81645 | |
| Store at 4°C short term. For long term storage, store at -20°C, avoiding freeze/thaw cycles. | |
| Liquid |
| Immunohistochemistry (Paraffin) | |
| 1 mg/mL | |
| PBS with 0.1% sodium azide | |
| P06199, P08172, P10980, P41985, Q9ERZ4 | |
| CHRM2 | |
| Synthetic 16 amino acid peptide from 3rd cytoplasmic domain of human CHRM2. | |
| 50 μg | |
| Primary | |
| Human, Mouse, Rat, Canine, Rabbit, Monkey, Bovine, Sheep, Hamster, Pig, Guinea Pig, Bat | |
| Antibody | |
| IgG |
Product Content Correction
Your input is important to us. Please complete this form to provide feedback related to the content on this product.
Product Title
Spot an opportunity for improvement?Share a Content Correction